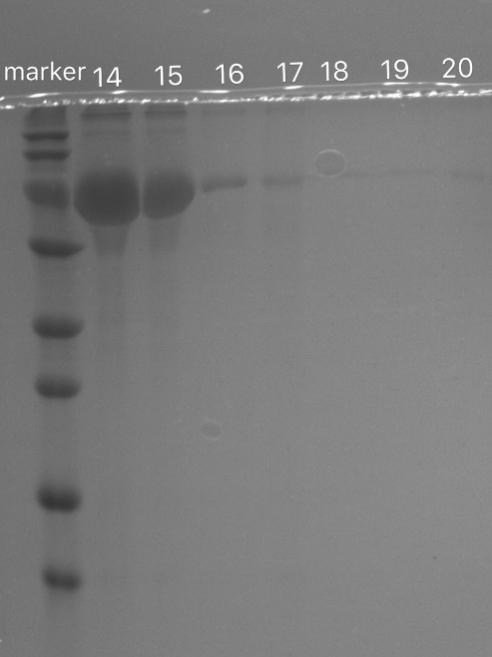

用于蛋白类药物靶向的磁性微珠研究毕业论文
2020-04-10 14:47:08
摘 要
植入体的体内抗菌一直是临床上棘手的问题,这是因为细菌可以形成生物膜保护细菌免受抗菌剂的作用,所以生物膜的降解是解决植入体体内抗菌的关键。磁性微珠由于其磁场导向特性在药物靶向方面得到了广泛应用,修饰过的磁性微珠可以用于负载蛋白质类药物,国内关于磁性微珠负载可降解生物膜的蛋白质的相关研究还不多,本文即是关于应用于负载可降解生物膜的蛋白质类药物的磁性微珠的研究。
本论文通过实验研究了磁性微珠的制备、多巴胺包被、镍离子螯合以及蛋白质负载。通过采用共沉淀法制备Fe3O4磁性微珠,该磁珠以后简称为磁性微珠,再在磁性微珠上包被多巴胺自聚物,得到PDA-MNPs,以后称为复合磁性微珠。在包被过的磁性微珠表面耦合Ni2 ,得到Ni2 -PDA- MNPs,以后称为载Ni2 复合磁性微珠,另外做了其他两种载Ni2 复合磁性微珠:水热法制备的载Ni2 复合磁性微珠(包被PDA前用柠檬酸钠处理)、载Ni2 复合磁性微珠(耦合Ni2 后用柠檬酸钠处理),和之前制备的PDA- MNPs、Ni2 -PDA- MNPs一起,以后统称为载体。经TEM、红外光谱、XRD等手段表征,所制备的磁性微珠粒径较小,磁性较好,多巴胺已包被于磁性微珠表面,多巴胺层厚约5nm左右。磁性微珠在包被多巴胺前后,晶体结构没有改变。然后利用获得的载体负载蛋白质,研究发现,制备的载Ni2 复合磁性微珠可以较好地负载BSA,BSA可以在载Ni2 复合磁性微珠上用咪唑洗脱下来。带组氨酸标签的DspB负载于载Ni2 复合磁性微珠后也可以洗脱下来,但是不能完全洗脱,载Ni2 复合磁性微珠对细菌裂解液的负载选择性不高,非特异性结合比较严重,用上述四种载体负载细菌裂解液,发现这四种载体的选择性普遍不高,原因还有待进一步探索。
关键词:Fe3O4磁性微珠 PDA包被磁性微珠 载Ni2 复合磁性微珠 植入体体内抗菌
Abstact
In vivo antibacterial of implants has always been a clinically difficult problem because bacteria can form biofilms to protect bacteria from the effects of antibacterial agents, so biofilm degradation is the key to obtain antibacterial effect in implants. Magnetic beads have been widely used in drug targeting because of their magnetic field-directing properties. Modified magnetic beads can be used to load protein drugs. There are not many studies on proteins that degrade biofilms loading by magnetic beads in China. This article is about the study of the use of magnetic microbeads loading proteins which degrade biofilms.
In this dissertation, magnetic bead preparation, dopamine coating, nickel ion coupling and protein loading were studied experimentally. Fe3O4 magnetic beads are prepared by a co-precipitation method. The magnetic beads are referred to as magnetic beads later, and then the dopamine self-polymer is coated on the magnetic beads to obtain PDA-MNPs, hereinafter referred to as composite magnetic beads. Ni2 -PDA- MNPs were obtained on the surface of coated magnetic beads, Ni2 -PDA- MNPs were later called Ni2 composite magnetic beads, and two other Ni2 -composite magnetic beads were also prepared: Ni2 composite prepared by hydrothermal method. Magnetic beads (coated with sodium citrate before PDA) and Ni2 composite magnetic beads (treated with sodium citrate after Ni2 coupling), together with previously prepared PDA- MNPs and Ni2 -PDA- MNPs, are collectively referred to as Carrier. The TEM, infrared spectroscopy, XRD and other means of characterization, the prepared magnetic microbeads smaller particle size, good magnetic properties, dopamine has been coated on the surface of magnetic beads, dopamine layer thickness of about 5nm. Before and after magnetic bead coated with dopamine, the crystal structure did not change. Then, using the obtained carrier-loaded protein, it was found that the Ni2 -loaded composite magnetic microbeads can be loaded with BSA, and BSA can be eluted with imidazole on Ni2 - loaded magnetic microbeads. After the DspB with histidine tag was loaded on Ni2 composite magnetic beads, it could also be eluted, but it could not be completely eluted. The loading of Ni2 composite magnetic microbeads on the bacterial lysate was not highly selective, and the non-specific binding was severe. The use of the above four carriers to load the bacterial lysate has revealed that the selectivity of these four vectors is generally not high, and the reason remains to be further explored.
Key words: Fe3O4 magnetic beads ;PDA-coated magnetic beads ;Ni2 - loaded magnetic beads; implant’s antibacterial in vivo
目录
第1章 绪论 1
1.1前言 1
1.2 植入体细菌感染的问题及解决方法 1
1.2.1 植入体细菌感染的发生及危害 1
1.2.2 植入体体内抗菌的研究现状 2
1.3 Fe3O4磁性微珠及复合磁性微珠的制备方法 3
1.3.1磁性微珠的制备方法 3
1.3.2磁性微珠的包被 4
1.4磁性微珠蛋白负载方法及应用 4
1.4.1 金属螯合作用 5
1.4.2应用 5
1.5 本论文的目的及意义 5
第2章 磁性微珠的制备及表征 7
2.1 引言 7
2.2 材料与方法 7
2.2.1 试剂与仪器 7
2.2.2实验方法 9
2.3 结果 11
2.3.1 载Ni2 复合磁性微珠的磁性 11
2.3.2 红外光谱分析载Ni2 复合磁性微珠组成 12
2.3.3 磁性微珠和载Ni2 复合磁性微珠的TEM 13
2.3.4 磁性微珠和载Ni2 复合磁性微珠的XRD 14
2.4 小结 15
第3章 载体负载蛋白质的研究 16
3.1 试剂与仪器 16
3.2实验方法 18
3.2.1 BSA标准曲线 18
3.2.2 载Ni2 复合磁性微珠对BSA的负载时间与其负载BSA量的关系 18
3.2.3 载体负载BSA及BSA负载效果的电泳检测 18
3.2.4 重组大肠杆菌(表达His-DspB)的培养 19
3.2.5重组大肠杆菌(表达His-DspB)的破碎 20
3.2.6细菌破碎液与载体反应的电泳检测 20
3.3结果与讨论 21
3.3.1 BSA标准曲线 21
3.3.2载Ni2 复合磁性微珠对BSA的负载时间与其负载BSA量的结果及讨论 22
3.3.3 载体负载BSA及BSA负载效果的电泳检测结果及讨论 23
3.3.4 重组大肠杆菌(表达His-DspB)的生长曲线 24
3.3.5细菌破碎液与载体反应的电泳检测结果与讨论 26
3.4 小结 27
第4章 总结与展望 29
参考文献 30
致谢 32
第1章 绪论
1.1前言
磁性微珠的磁场导向特性使其在药物靶向方面得到广泛应用,在生物医药领域,磁性微珠磁性纳米颗粒作为负载各种抗癌药物的载体被广泛研究[1],以期形成磁场导向的给药系统。植入体材料一直是临床上解决很多问题的办法,但是植入体常发生细菌感染,所引起的感染在临床上处理起来较为困难,因此体内植入体材料的表面抗菌一直是人们试图解决的问题。植入体材料的体内感染难以根除,主要是因为植入体材料与人体内环境接触时,细菌可生长繁殖形成一层顽固的生物膜[2],生物膜主要由细菌分泌的胞外聚合物相互粘连形成,它不仅能有效促进细菌在生物膜表面的黏附,更重要的是它可以抵抗一般的抗生素等抗菌药物保护细菌,让细菌的体内感染难以根治。所以通过降解生物膜可以达到更有效的抗菌的目的。利用磁性微珠负载细菌生物膜的降解酶或其他具有抗菌性能的蛋白质类药物,使其在能发挥其抗菌作用的同时可以在磁场存在的情况下进行靶向响应及定位,目前国内关于这方面的研究还较少,本文将利用改性的磁性微珠负载可降解生物膜的蛋白质类药物,以期解决植入体细菌感染问题。
1.2 植入体细菌感染的问题及解决方法
1.2.1 植入体细菌感染的发生及危害
随着人口老龄化及中青年创伤的增多,植入体的应用越来越广泛[4],在临床上,关节置换、心脏搭桥等都要在体内进行植入体的运用,越来越多的创伤、脊柱和骨关节病患者接受了金属内固定、矫形和人工关节置换等手术[5]。而在植入体的植入过程中,容易发生植入体的细菌感染,金属材料植入人体时可能带入空气中、术者或患者体表的葡萄球菌等病原体,患者手术后也可能因常见的皮肤软组织感染、呼吸道感染或泌尿生殖道感染等引起植入物相关感染。Von Eiff C等人的研究表明,金黄色葡萄球菌和表皮葡萄球菌是引起骨科植入器械感染的主要细菌[6]。
进入人体内的细菌容易黏附在植入体材料表面,繁殖并分泌胞外聚合物,菌群扩大,胞外聚合物相互粘连,最终形成生物膜。这层生物膜不仅能有效促进细菌在表面的黏附,更可以保护细菌免受抗菌剂和人体免疫系统的杀灭作用,从而导致体内细菌感染的难以根治[7]。生物膜一旦形成,细菌可对抗生素产生高度的耐药性,而这一高度的耐药性与胞外聚合物的多网状屏障结构密切相关。生物膜的胞外聚合物包含胞外多糖(EPS)、蛋白质等。当生物膜的胞外聚合物被破坏,细菌从生物膜中分散出来成为浮游菌,将有利于抗生素等杀菌剂对生物膜的清除[3]。
体内细菌感染不仅会引起局部组织破坏、病原体的全身播散和植入物的失效,还可能导致严重疾病甚至死亡[4]。
1.2.2 植入体体内抗菌的研究现状
1.2.2.1 表面改性抗菌金属材料的研究
目前对植入体材料的表面抗菌研究主要有三个方向:(1)以抗黏附高分子修饰植入体表面, 预防细菌的初始黏附;(2)在植入体表面固定可释放的抗菌剂,杀死黏附在其表面或在其表面附近的细菌;(3)构建杀菌植入体表面,杀死植入体表面黏附的细菌[7]。
(1)抗黏附高分子修饰植入体表面:活细菌在植入体材料表面的初始黏附是生物膜形成的必要条件。对植入体材料进行表面改性,赋予植入体抗细菌黏附的性能是植入体表面抗菌的有效策略之一。例如:聚氧乙烯(PEG)具有亲水性好、运动性高、排斥体积大等优点,有研究表明,PEG改性表面能在短期内降低细菌的黏附。(2)在植入体表面固定可释放的抗菌剂:在植入体材料本身或表面涂层加入各种小分子抗菌剂,比如杀菌剂、抗生素、季铵盐化合物、银离子、碘等,使用时抗菌剂释出杀灭周围介质或材料表面吸附的细菌。在植入体表面加入抗生素,对细菌的杀灭具有特异性,而且容易诱导细菌产生抗药性,不适合杀灭多种细菌。银离子具有广谱杀菌特性,不会诱发抗药性,毒性小,因此作为植入体材料内部或表面的释放型抗菌剂被广泛应用。但是银离子释放速度过快且不易调控,目前有研究者提出在材料表面原位生成银纳米粒子来克服这一问题。(3)构建杀菌植入体表面:将抗菌剂固定在植入体表面达到抑制黏附在表面的细菌生长和杀灭表面细菌的作用,.聚阳离子是一类广为研究的抗菌高分子,将其固定于植入体表面可以构建接触杀菌表面,它比小分子抗菌剂具有更大的表面固定量,更高的抗菌活性,有关这方面的研究广受关注[7]。徐志康等人借助紫外光诱导接枝DMA EMA 和季铵化或季铵化-交联反应,为聚丙烯微孔膜构建了基于聚阳离子改性的抗菌表面,测试了其抗菌性能,发现未经交联的聚阳离子对大肠杆菌和金黄色葡萄球菌都具有较强的抗菌性能,且随表面正电荷密度提高或接触时间的延长而增强,但是一旦交联则抗菌性能丧失,提高电荷密度和延长接触时间均对其恢复没有帮助。
1.2.2.2 植入体细菌感染问题的另一种解决方案
由于表面改性金属材料并不能做到完全消除细菌感染,细菌在生物膜的保护下依然难以根除。所以解决植入体体内抗菌问题的关键在于生物膜的降解,之后再用抗菌剂对细菌进行杀灭处理。细菌自身合成的胞外多糖是生物膜抵抗抗菌物质和宿主免疫成分的重要保护屏障,因此降解胞外多糖或抑制其合成是目前研发抗生物膜药物的热点之一[10]。分散蛋白(dispersin,Dsp)B是一种近年来在牙周可疑致病菌伴放线嗜血杆菌生物膜中发现的具有降解胞外多糖功能的β-己糖苷酶。DspB可以有效降解胞外多糖,使细菌从生物膜中分散出来,达到有效降解生物膜的功能,从而控制植入材料的感染[10,11]。对于生物体而言,通过酶降解细菌生物膜相对前述的抗菌用的化学物质来说可以减轻对机体的伤害。
胞外多糖的降解是解决细菌感染问题的好方法,但是对于植入体而言,降解酶靶向植入体表面却是一个困难,一种方法是将降解酶固定于植入体表面,另一种方法是将降解酶靶向导入到植入体表面。本论文着眼于第二种方法,把降解酶负载于磁性微珠上,在磁场的引导下将降解酶靶向于植入体。
1.3 Fe3O4磁性微珠及复合磁性微珠的制备方法
1.3.1磁性微珠的制备方法
目前, 用于合成磁性微珠的方法有多种, 比如水热反应法、共沉淀法、中和沉淀法、沉淀氧化法等[11]。其中比较常用的是共沉淀法和水热反应法。
共沉淀法主要是将二价铁盐和三价铁盐按照一定比例混合,并在 氮气的保护下加入通常为氨水或氢氧化钠溶液的碱性溶液,在适宜的温度和pH条件下反应一定时间后,再经过过滤、洗涤、干燥后即可获得磁性微珠。Liu等以FeCl2和FeCl3为原料,N2保护下加入氨水,通过共沉淀法制备了平均粒径小于 l5 nm的磁性微珠,其具有良好的超顺磁性[1]。周小丽等以FeCl2•4H2O和FeCl3•6H2O为原料,采用水热法合成了磁性微珠磁性纳米微粒,实验结果表明得到了形貌和粒径比较均匀的磁性Fe3O4纳米微粒[12]。
与水热法相比,共沉淀法对实验条件的要求更为简单,所以更为常用。
1.3.2磁性微珠的包被
在制得分散性良好的磁性微珠后, 用功能性的高分子材料对磁性微珠进行表面修饰, 得到包被的磁性微珠。
以上是毕业论文大纲或资料介绍,该课题完整毕业论文、开题报告、任务书、程序设计、图纸设计等资料请添加微信获取,微信号:bysjorg。
相关图片展示:

课题毕业论文、开题报告、任务书、外文翻译、程序设计、图纸设计等资料可联系客服协助查找。
